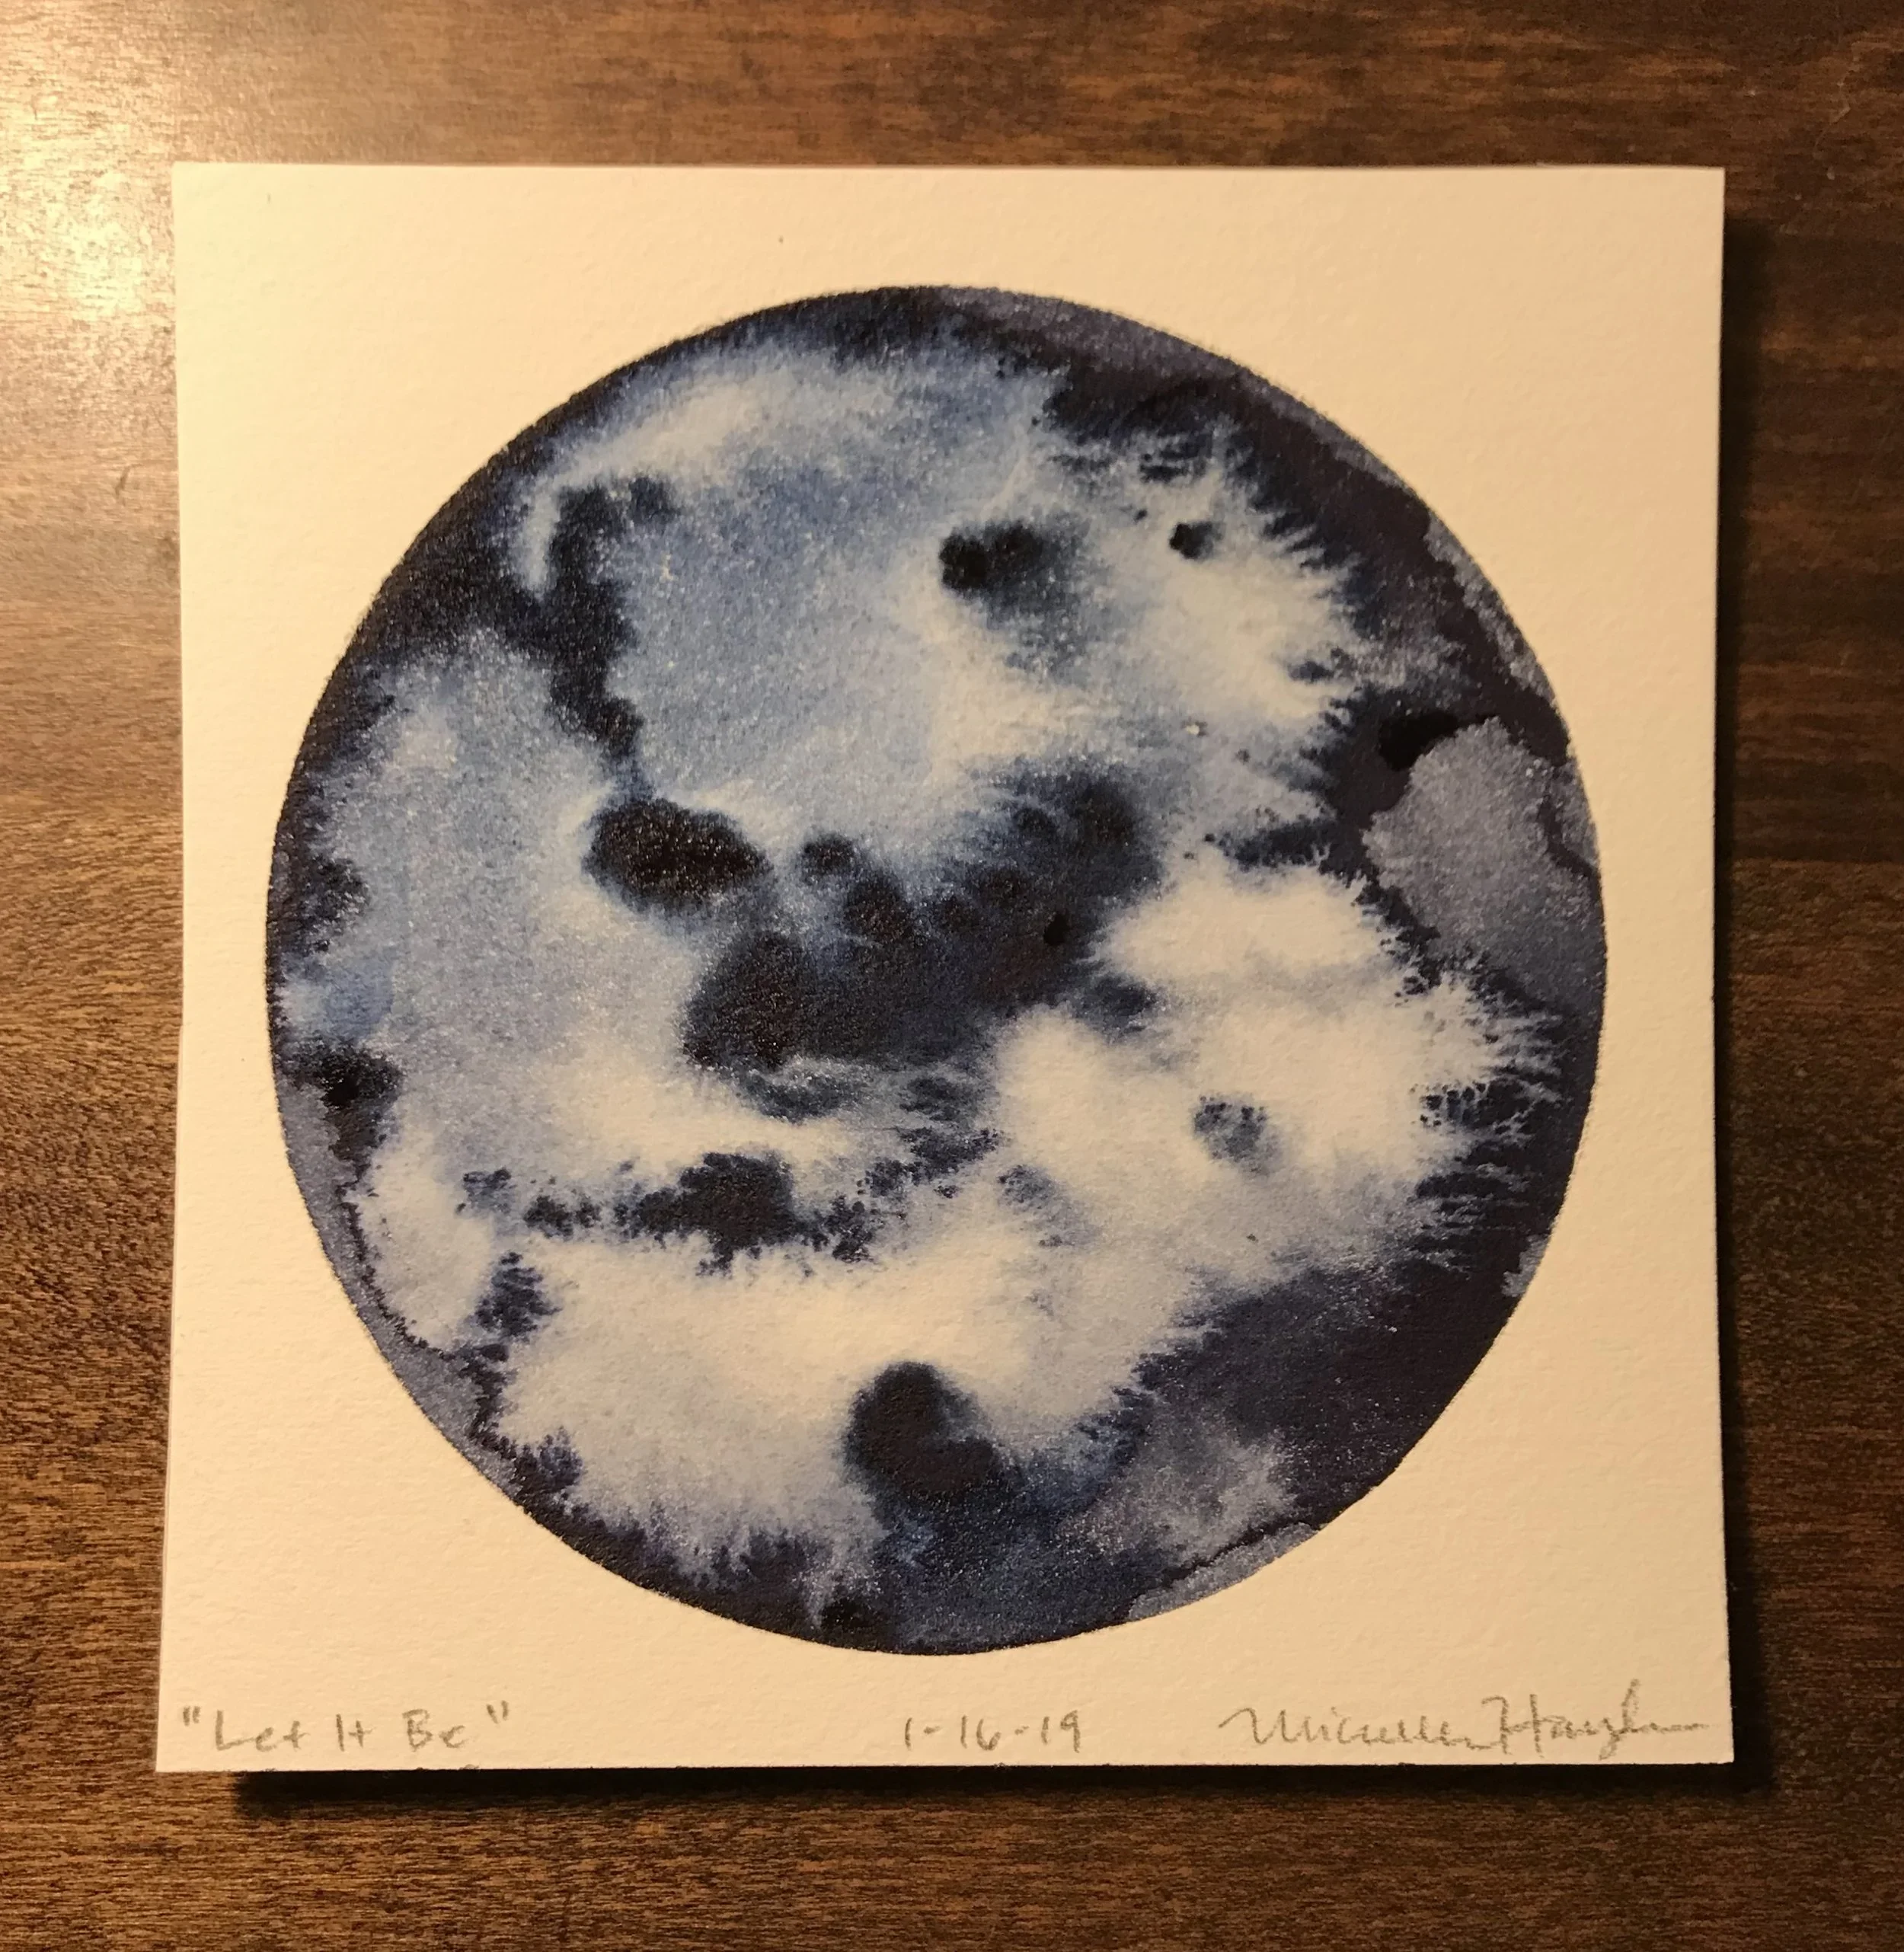

Wonder Round (January 6-26, 2019)
My goodness, how time has flown for the past three weeks as I have been immersed in preparing for, installing, and being present for my show, “Beyond”, which runs until February 14th at the Mill and Max Contemplative Arts Gallery at the Shambhala Center of Lexington. I have reflected many facets of the experience in the circles, below, which was a nice way to document the experience, which has been full and deep for me. Gratitude for all of the learning that has transpired on so many levels is the predominant feeling that stays with me. Thank you all for following along so supportively!
As the due date looms near for hanging my first solo show (vs. “deadline”... an intentional change in chosen word suggested by a wise soul, connecting to positive energy in what is yet to come), I am noticing a shift... Never having set up an exhibit before, let alone of my own work, I have carried a fair bit of anxiety as I wondered what the completed space would be like in the gallery (it is beautiful), which work would make the final cut to be placed into that space, and the details of the many logistics involved in preparing for a show. My mind has not been a quiet place. But slowly, I have been making lists (and checking them twice— or ten times) and crossing things off one at a time. By doing so, while implementing a more active meditation practice, I have noticed that the anxiety is lessening and being replaced by relief and excitement as the date draws near. Pouring over my inventory of encaustic sculpture has had the unexpected benefit of introspection as I recall the meaning of each piece, the circumstances of my life at the time made, and awareness of what has changed since the making. As I gear up for all that must transpire in the next 2 weeks leading up to the opening, I am focusing on gratitude for this process of growth.
As we were gifted by another day of sunshine yesterday, I went on a second walk in the afternoon, soaking up the warmth and soothing of the rays on my skin. It felt energizing, calming, and full of hope, even for the number of minutes I had available to stroll. It is amazing to me— the effect of light in our lives— both natural and that which is shared in exchanges with each other. Sending vibrant healing energy to all of you, no matter the amount in your sky today...
This is all I could muster this morning, as not every day is filled with endless energy. Still, we all get up every day and do the best we can with what we have. Wishing you all the energy to get back up on the horse in whatever ways are needed today, surrounded by the knowledge of being human and the light of being loved.
The unconscious comes in handy sometimes... this one arrived to remind me to break through the surface of what surrounds and come up for air. So simple to do, yet difficult to remember in the midst of intense focus and concentration... more lessons in balance!
As I head into town to begin installation of my art, I am aware of the many working parts that have come together to arrive at this point. I am grateful to my children and spouse for their patience, love, and sacrifice of my presence throughout the prolonged preoccupation involved while creating the work and organizing the details, and to my family and friends who have shown understanding, support, encouragement, and hands-on help. I am thankful for the members of the Shambhala Center in Lexington, who have had faith in the long process of renovation as well as in my art, and have worked tirelessly to enable the installation a week before the opening. Here’s to hoping the day unfolds like clockwork :).
My only painting goal this morning was to complete my circle before the kettle boiled for tea, which made me laugh as I threw caution to the wind and got to work. It was quite freeing to know I would not labor over word or image today, saving energy to return north and continue working. Finding small pickets of release are a great start to any day, hoping we all do this more often!
After thirteen direct hours Thursday and nine more yesterday, all of the artwork is now on the walls or suspended from 14 foot ceilings... level, secure, and happy. Figuring out a wire suspension presentation system with flat artwork is challenge enough, so being able to successfully do so with sculptural work (after countless experiments that left us with a mixture of frustration, laughter, and persistent steam coming out our ears as we tried attempt after attempt to pull the work flush against the wall), was no small thing. And I could not have done it alone. I am indebted to the brain workings and moral support of all who had hands and minds involved in that coming to fruition! “Triumphant” is the word that popped into my head as I climbed into my car late last evening... and not in a grandiose sense, but in the simple sense of sticking with an overwhelming task until completion, aware of the power of group in being able to proclaim it complete. I will use this boost of energy for my tired body as I dig into the tasks of repairing a large sculpture damaged in return shipping and the preparation of words that I decided will accompany my art, after all... Thank you all for following along in this process with me.
Over and over gain, I am struck by the power of connection... how we offer balance, support, and love to one another through all kinds of times in our lives. Sharing my vulnerabilities with others has taken long and careful tending (as it does for us, all) and gifted me back tenfold, the fear involved in the opening. May we all be bolstered by the safe nurturance offered by one another...
One thing that is most always true for me, is that things take way longer than I think they will... after spending the entire weekend repairing the sculpture and writing and printing statements for each of the 33 pieces in the show, I am beginning to see light peeking in after all are placed on the walls today. I decided that the Mill and Max Contemplative Arts Gallery at the Shambhala Center holds a unique opportunity for the holding of words that is not often included an exhibit. It was worth the time to reflect on and refine what I had written about each piece, and my hope is that the words will bring further contemplation, acting as bridge with the viewers who ponder their connection to the artwork.
Feeling gratitude for the sensation of peace this morning, I send it out to all of you before I leave to finish up the last remnants for the exhibition. I am looking forward to taking time after putting up (very) last minute flyers and taking care of some neglected computer work to photograph all of the installed work. It has been an interesting emotional process to go from these pieces living alongside the fullness of life in our home to becoming a collective that rests in spaciousness. I realized that I need alone time to sit quietly and be with my art today, reflections of years’ worth of inner work that are now external. I said to my friend last night that it feels like being inside-out and is a bit startling— but more than that, it gives me perspective and allows objectivity to see the journey of getting to this place in my life. I think if we each had the chance to step back and take in the paths that have led us to where we now stand, that we would connect with more compassion for ourselves and each other...
One thing I have repeatedly been reminded of as of late is the obvious fact that I do not have control over all that happens in a day. As I have aged, some times a peace comes with this truth and a settling in to what evolves... at times, there is even relief and joy at seeing the blooming of what I could not have imagined. Other times, there is hard work to do on acceptance of outcomes I would not wish to choose. It is a balance for us all, as we navigate day by day. This morning, I decided to use only one color and to let the water dictate the flow. It was relaxing to paint this way, with little thought to composition, allowing the paint and water to land and move where they wanted to go, much like the clouds passing overhead in the sky...
What a difference it makes to start the day in silence, soaking up spaciousness and calm and possibility. That is one thing that painting the circles has done for me— grounding me in stillness after getting out of bed, rather than hitting the ground, running. It is gentle for the mind, spirit, and body, and there when called on through breath and intention— a simple gift.
This morning as I lie awakening, I reflected on the hours of my life that have led to the opening of my exhibit today— they are many in number and have transpired over years of work, inner and outer. As the years have unfolded and my marriage grew to bring two children into the world, my hours were infused with the care and raising of our boys. Now that they are old enough, they have nurtured me with their dad by giving of their time and energy to support the intense focus needed to grow my art, as have many friends and family. It is a privilege to have today arrive and I am brimming with excitement that is steeped in gratitude that it has come to fruition. Thank you all for the outpouring of love, encouragement, and enthusiasm that you have so generously shared with me!
What a joy to share that the opening last evening was a most lovely and successful event! It was so exciting to be greeted by friends, family, and the many new folks whom I met... a sweet balance of lively and relaxed, steeped in engagement. It was an enlivening experience to watch others react to the work (especially the sculptural mobiles that were in gentle motion) and was delightful for me. I deeply appreciated those that could attend and felt the love and support from afar from those that could not. Several pieces will be going home with others, which is wonderful, as well, and hearing the connections behind the chosen pieces was very meaningful. Today, I step into the artist talk as it starts off the afternoon for the grand reopening of the beautiful Shambhala Center that houses the art gallery. As my friends reminded me last night, all I have to do is speak from the heart about what I love to do— I hope I can remember that when the time comes!
How exciting to wake up this morning with no expectation for the day, other than to sink into the feelings of relief and gratitude for all that has transpired in the last few days. I am happy to say that the talk went well, encouraged and supported by the wonderful group of people that came and engaged in thoughtful questions as I shared about my life and my work. The afternoon continued to blossom with deep discussions with many individuals, and I thoroughly enjoyed that aspect of sharing and growing from one another. Hooray for the arts for connecting us in this path of life! I could not be happier today to have some time to ponder what I have learned from this whole experience and to allow myself to relax into space without a list, tea in hand and a fire soon to be in the wood stove. First, though, an exhilarating walk into freshly fallen snow!
It is funny how our bodies and minds can rebel against the inevitable task of getting out of bed, knowing much awaits at the beginning of any week. This morning I watched the moon set outside one window and the sky lighten in the other, toasty warm and grateful under a heavy stack of blankets. As I shuffled over to the painting desk that looks out on daylight (unusual!), I took comfort in the ease of the “doodle”, reminding myself that like the days and weeks that need attention, one mark after another will get us to where we need to be. Wishing you all an easing into your days...
As I passed the woodpile en route to the hills with doggie in tow this morning, my eyes were drawn to the strong pattern of rings that were illuminated by the morning light. As I meandered along in the loud crunch of boots on frozen snow, I contemplated how each ring radiates out from its core, growing wider and stronger as the core gets farther and farther removed from the edge, yet there all along. How much like trees we are, our layers built up over time through all sorts of experiences... and how easy it is to forget we are pure and strong at our core. I believe it is always there, continuing to help us grow outward from the basic goodness that has been present from the beginning, if we can just see it. Wishing connection to this foundation within all...
Last evening we gathered around a rickety card table and played Tenzi, a speed game of rolling dice, ten each for a total of forty... the noise against the plastic of the table was near deafening. After “losing” round after round and blaming it on not being able to concentrate, lol, I placed a very old wooden card table top on top of it, and it was like magic (although I did not proceed to repeatedly win). It was interesting to see how we were able to not only focus and relax, but to free up energy to laugh and enable ease to emerge, which was highly contagious, of course. It made me think of how we are influenced by our surroundings every day, and how challenges both in the environment and in our own minds can affect us in ways much more serious than a dice game. I wish there were a way to quiet the noise that interferes with basic life for so many...
When I walk the land before the sun has illuminated the sky, I am often quite startled by the sound of wings, quickly making an escape out of the tall grasses that lay feet away from my own. I do not know the name of the bird that flies, having no light to see anything but the blur of wings, and I suppose the name is not important. I always feel sorry for having disturbed it’s place of nightly rest and refuge, and wonder how that must feel to be only surrounded by small blades of scrubby ground cover. Perhaps it is being close to the ground after depending on wings all day that matters the most...
Another critter appeared today, mirroring the vibrant sunshine that woke me, long past my usual waking hour. What a gift, this light... a reminder to soak up its essence and to pass it on to those we meet in our days.